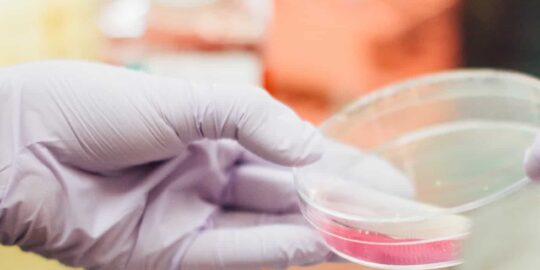
placeholder

Shortcodes
Progress Bar
Call to action
Accordion and tabs

What Corey Burnham can offer you is more than just a personal trainer service. He can offer you a whole new lifestyle.

What Corey Burnham can offer you is more than just a personal trainer service. He can offer you a whole new lifestyle.

What Corey Burnham can offer you is more than just a personal trainer service. He can offer you a whole new lifestyle.
I don’t know what kind of lives John McCain thinks that celebrities lead, but this has been mine. We are taking concrete actions to change course. That is not how moral authority is claimed; that is how it is surrendered. I wanted to be part of something larger. Because the Iraq war is not just a security problem, it’s a moral problem.

I don’t know what kind of lives John McCain thinks that celebrities lead, but this has been mine. We are taking concrete actions to change course. That is not how moral authority is claimed; that is how it is surrendered. I wanted to be part of something larger. Because the Iraq war is not just a security problem, it’s a moral problem.

I don’t know what kind of lives John McCain thinks that celebrities lead, but this has been mine. We are taking concrete actions to change course. That is not how moral authority is claimed; that is how it is surrendered. I wanted to be part of something larger. Because the Iraq war is not just a security problem, it’s a moral problem.
Boost Your Metabolism
Why does eating lots of fish rich in omega-3 fatty acids (salmon, herring, and tuna) help amp up metabolism? Omega-3s balance blood sugar and reduce inflammation, helping to regulate metabolism. They may also reduce resistance to the hormone leptin, which researchers have linked to how fast fat is burned. A study in Obesity Research found rats that ingested large doses of fish oil while exercising lost weight. Take omega-3 fatty acid supplements; Hyman recommends 1,000 to 2,000 milligrams per day. Hate the fishy after-burp? Try flaxseed oil, walnuts, or eggs fortified with omega-3s. Or check out supplementsthat have no fishy taste.

Challenge yourself
Why does eating lots of fish rich in omega-3 fatty acids (salmon, herring, and tuna) help amp up metabolism? Omega-3s balance blood sugar and reduce inflammation, helping to regulate metabolism. They may also reduce resistance to the hormone leptin, which researchers have linked to how fast fat is burned. A study in Obesity Research found rats that ingested large doses of fish oil while exercising lost weight. Take omega-3 fatty acid supplements; Hyman recommends 1,000 to 2,000 milligrams per day. Hate the fishy after-burp? Try flaxseed oil, walnuts, or eggs fortified with omega-3s. Or check out supplementsthat have no fishy taste.

Boost Your Metabolism
Why does eating lots of fish rich in omega-3 fatty acids (salmon, herring, and tuna) help amp up metabolism? Omega-3s balance blood sugar and reduce inflammation, helping to regulate metabolism. They may also reduce resistance to the hormone leptin, which researchers have linked to how fast fat is burned. A study in Obesity Research found rats that ingested large doses of fish oil while exercising lost weight. Take omega-3 fatty acid supplements; Hyman recommends 1,000 to 2,000 milligrams per day. Hate the fishy after-burp? Try flaxseed oil, walnuts, or eggs fortified with omega-3s. Or check out supplementsthat have no fishy taste.

